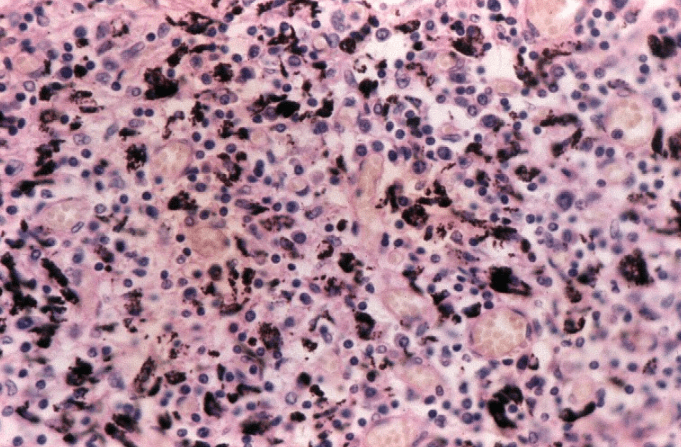

Da «click» sobre las imágenes para agrandarlas y consultar sus leyendas.
EPITELIO OLFATORIO
La mucosa olfatoria se conforma de un epitelio cilíndrico seudoestratificado ciliado.
Contiene 4 tipos de células:
1. Células olfatorias
2. C. sostén
3. C. basales
4. C. en cepillo




TRÁQUEA
El epitelio cilíndrico seudoestratificado ciliado con células caliciformes se ubica en la TRÁQUEA, BRONQUIOS y LARINGE también es llamado «Epitelio respiratorio»










BRONQUIOS











BRONQUIOLOS



ALVÉOLOS